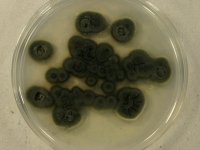

<< back to search results
IMAGES:








Search Details
add to cart
| UAMH Number: | 11285 |
|---|---|
| Species Name: | Hyaloscyphaceae sp. |
| Type: | |
| Synonyms: | |
| Taxonomy: | FUNGI Ascomycota, Leotiomycetes, Helotiales, Hyaloscyphaceae |
| Strain History: | Grelet, G.A. (AC5) -> UAMH |
| Substrate: | Calluna vulgaris hair roots | Location: | UNITED KINGDOM England, Devon, Exeter, Aylesbeare Common (GEO: 50.707,-3.328) |
| Isolator: | J.M. Sharples, (C) G.A. Grelet |
| Isolation Date: | 1998-01-01 |
| Date Received: | 2010-09-13 |
| Characters: | MYCORRHIZAE ericoid mycorrhiza - Grelet GA; Mehargi AA, Duff EI, Anderson IC, Alexander IJ, New Phytologist 181: 708-718, 2009 // MYCORRHIZAE ericoid mycorrhizal fungi - Grelet GA; Mehargi AA, Duff EI, Anderson IC, Alexander IJ, New Phytologist 181: 708-718, 2009 (Click for publications citing UAMH 11285) |
| Compounds: | |
| Cross Reference: | IMI 392570 |
| Collections: | Living Strains; Dried Herbarium Material |
| Pathogenic Potential: | Human: no | Animal: no | Plant: no |
| Biosafety Risk Group: | RG1 (check the PHAC ePATHogen Risk Group Database for updates) |
| Regulatory Requirements: | Canadian requesters must provide PHAC Pathogen and Toxin License Number (see: https://www.canada.ca/en/public-health/services/laboratory-biosafety-biosecurity/licensing-program.html) prior to shipment. International requesters must provide all legally required importation documentation prior to shipment. Plant pathogenicity status may be verified by using the USDA Agricultural Research Service (ARS) Fungal Database |
| MycoBank ID: | 80871 |
| Sequences: | >UAMH11285_FM180480_SSU CATTACCGAGTTCATGCCCTAACGGGTAGATCTCCCACCCTCTGTTATCATTACCTTTGTTGCTTTGGCGGGCCGTCAGGCCCCGGTCAGGCTACCGGCTTCAGCTGGTAAGCGCCCGCCAGAGGACCCTAAACCCTGAATATCAGTGTCGTCTGAGTTCTATGTAATCGTTAAAAACTTTCAACAACGGATCTCTTGGTTCTGGCATCGATGAAGAACGCAGCGAAATGCGATAAGTAATGTGAATTGCAGAATTCAGTGAATCATCGAATCTTTGAACGCACATTGCGCCCCTTGGTATTCCGAGGGGCATGCCTGTTCGAGCGTCATTACAACCCTCAAGCACTGCTTGGTCTTGGGCTCCGCCGCTAATCTGGCGGGCCTTAAAATTAGTGGCGGTGCCGTCGGGCCCTGAGCGTAGTAAATCTCCTCGCTATAGGGTCCCGGTGGACGCTAGCCAGTAACCCCTATTTTCTATG |
IMAGES: